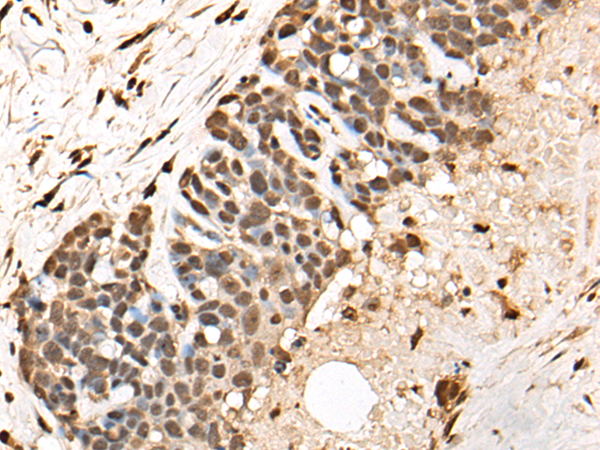

中文名稱: 兔抗BCL9多克隆抗體
|
Background: |
BCL9 is associated with B-cell acute lymphoblastic leukemia. It may be a target of translocation in B-cell malignancies with abnormalities of 1q21. Its function is unknown. The overexpression of BCL9 may be of pathogenic significance in B-cell malignancies. |
|
Applications: |
ELISA, IHC |
|
Name of antibody: |
BCL9 |
|
Immunogen: |
Fusion protein of human BCL9 |
|
Full name: |
B-cell CLL/lymphoma 9 |
|
Synonyms: |
LGS |
|
SwissProt: |
O00512 |
|
ELISA Recommended dilution: |
5000-10000 |
|
IHC positive control: |
Human thyroid cancer and human cervical cancer |
|
IHC Recommend dilution: |
25-100 |

購物車
幫助
021-54845833/15800441009
